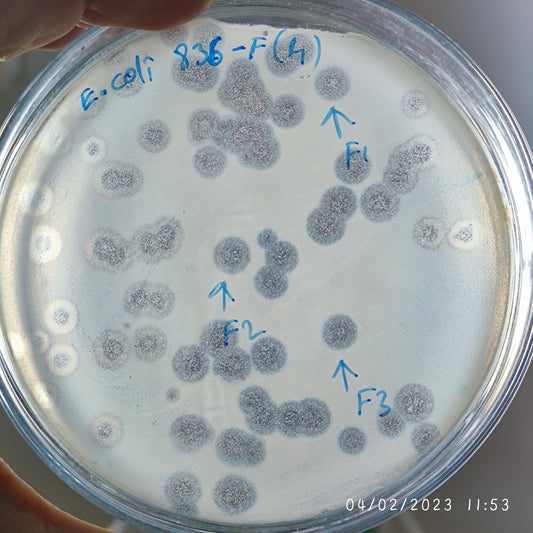
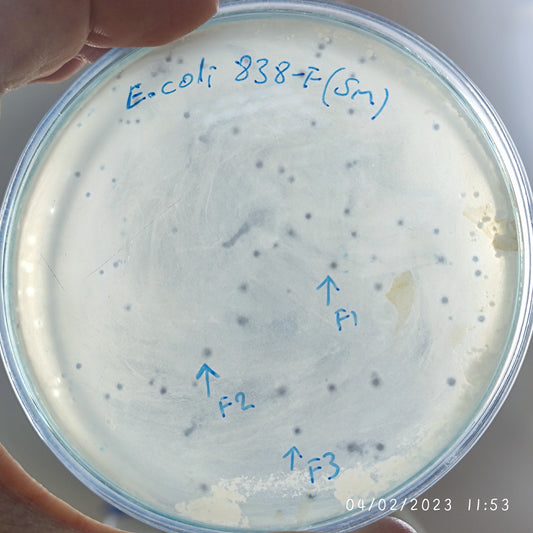
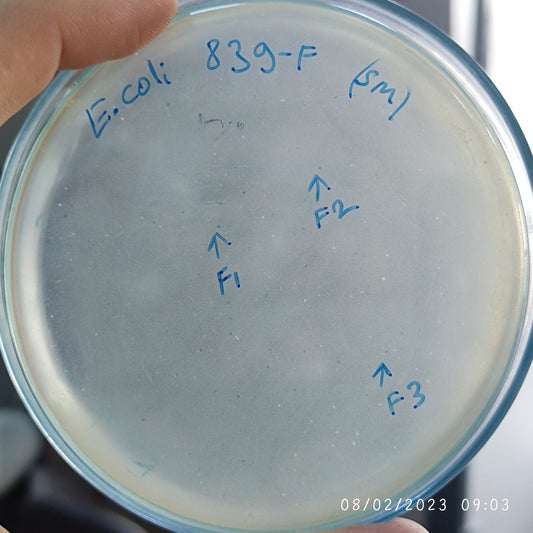
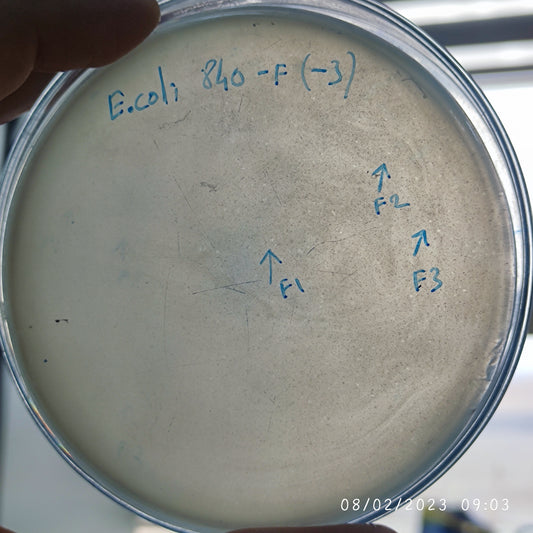
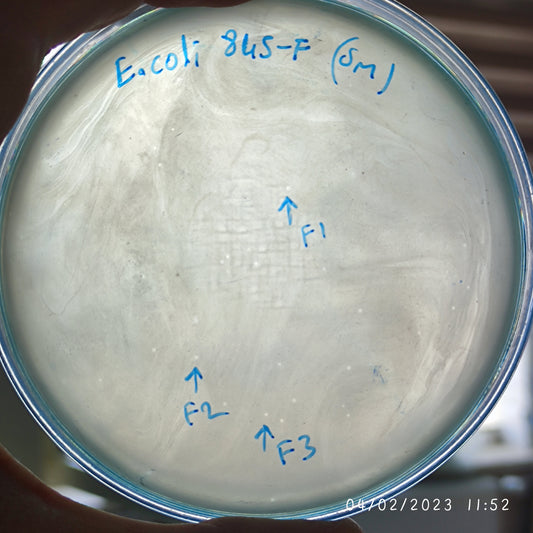
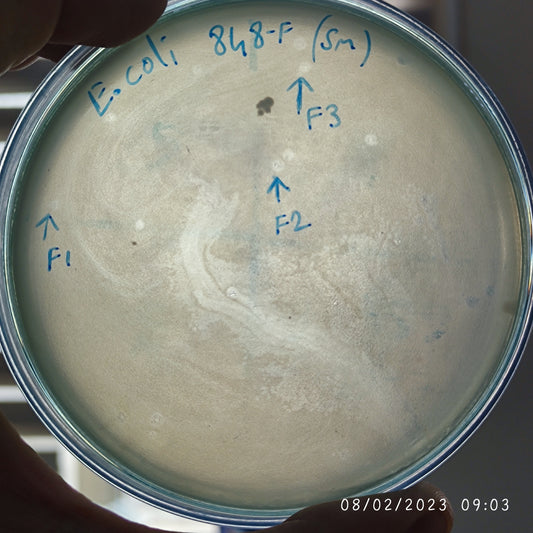
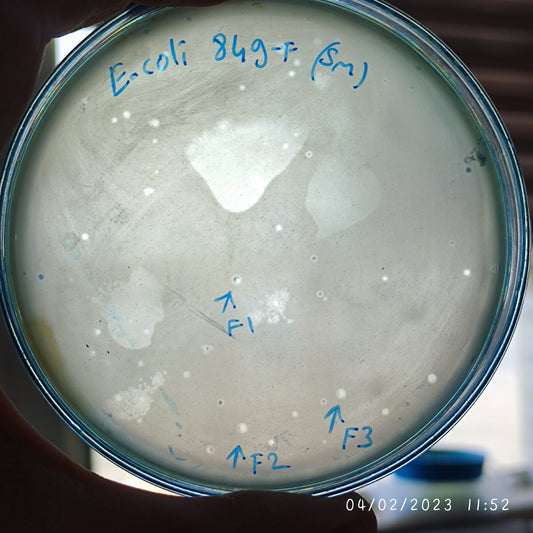
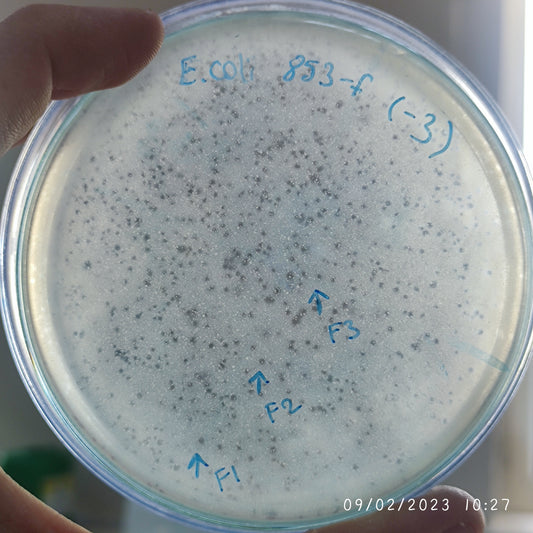
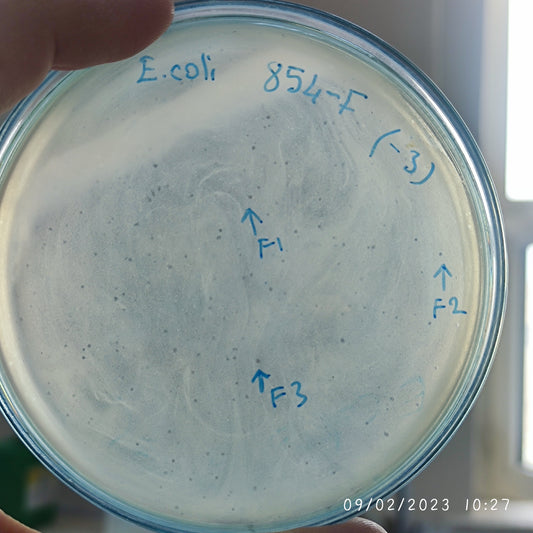

-
Escherichia coli bacteriophage 100833F
Regular price $900.00 USDRegular priceUnit price per -
Escherichia coli bacteriophage 100834F
Regular price $750.00 USDRegular priceUnit price per -
Escherichia coli bacteriophage 100836F
Regular price $900.00 USDRegular priceUnit price per -
Escherichia coli bacteriophage 100838F
Regular price $750.00 USDRegular priceUnit price per -
Escherichia coli bacteriophage 100839F
Regular price $750.00 USDRegular priceUnit price per -
Escherichia coli bacteriophage 100840F
Regular price $600.00 USDRegular priceUnit price per -
Escherichia coli bacteriophage 100841F
Regular price $750.00 USDRegular priceUnit price per -
Escherichia coli bacteriophage 100845F
Regular price $700.00 USDRegular priceUnit price per -
Escherichia coli bacteriophage 100848F
Regular price $750.00 USDRegular priceUnit price per -
Escherichia coli bacteriophage 100849F
Regular price $750.00 USDRegular priceUnit price per -
Escherichia coli bacteriophage 100850F
Regular price $750.00 USDRegular priceUnit price per -
Escherichia coli bacteriophage 100850G
Regular price $800.00 USDRegular priceUnit price per -
Escherichia coli bacteriophage 100852F
Regular price $750.00 USDRegular priceUnit price per -
Escherichia coli bacteriophage 100853F
Regular price $750.00 USDRegular priceUnit price per -
Escherichia coli bacteriophage 100854F
Regular price $750.00 USDRegular priceUnit price per -
Escherichia coli bacteriophage 100855F
Regular price $750.00 USDRegular priceUnit price per